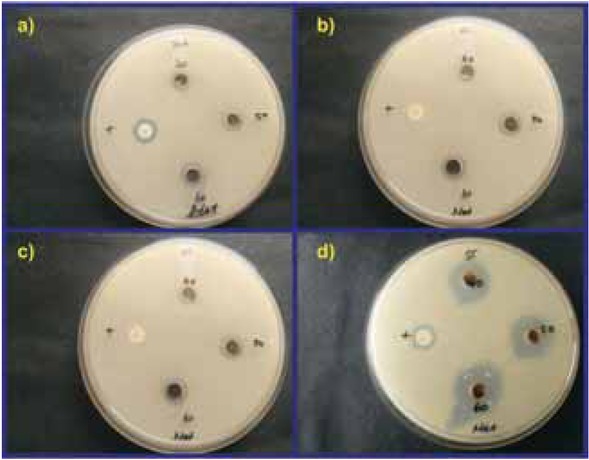

Facile synthesis of silver nanoparticles using Averrhoa bilimbi L and Plum extracts and investigation on the synergistic bioactivity using in vitro models
-
Suresh Sagadevan
, Selvaraj Vennila
Abstract
The bacterial communities (Gram-negative and Gram-positive) form the biofilms which oppose the mode of action of antibiotics and affecting the immune system of the human. These chronic infections related to biofilm are always hard to be cured because of their inherent resistance to both antimicrobial agents and host defense. The present study is devoted to the synthesis of silver nanoparticles (AgNPs) using aqueous extracts of Averrhoa bilimbi leaf and Plum fruit (Prunus bokharensis) and its inhibitory effect on Staphylococcus aureus, Escherichia coli, Pseudomonas aeruginosa, and Salmonella typhi. Here, AgNPs) were successfully prepared by green synthesis method obtained by the reduction of silver nitrate into silver ions. The synthesized AgNPs were characterized by UV-Vis Spectroscopy, XRD, FTIR, FESEM-EDAX and DLS analysis. The antimicrobial effects of the two extract were evaluated by the disk diffusion method. The green synthesized AgNPs exhibited good antibacterial activity against both Gram-negative and Gram-positive. They were also analyzed for their significant antibacterial activities against all the test cultures exposed whereas Escherichia coli and Salmonella typhi topped among other test cultures. The anti-proliferative activity of phytochemical mediated synthesis of Ag NPs was investigated for their cytotoxicity in Vero and Human epidermoid larynx carcinoma cell lines (HEp-2) based on their viability using MTT assay. The present study also represents the synergistic bioactivity of silver nanoparticles using in vitro models.
1 Introduction
Antibiotics are promising candidate in the treatment of bacterial/ microbial infection in humans. The existing role of medicine and their indescrimate use among human have resulted in the emergence of multidrug-resistant bacteria. But nowadays, due to the development of resistance of these micro-organisms against frequently use antibiotics these man-made synthetic antibacterial are not as much effective to act against bacteria. Development of drug-resistance among human is an immense challenge for pharmacist and researchers working on biomedicine due to fear of reemergence of bacterial infection [1,2]. As a result, a vast increase in the number of bacterial infections is observed mainly caused by microorganism growing in the form of biofilms. Gram-Positive and Gram-negative bacteria, both can form biofilms indwelling medical devices such as mechanical heart valves, prosthetic joints. Most commonly found biofilms formed by bacterial associates commonly with human diseases are Staphylococcus aureus, Escherichia coli, Pseudomonas aeruginosa, Salmonella typhi, Klebsiella pneumonia, Staphylococcus epidermis, Staphylococcus viridians, etc. [3,4]. Healing efficiency of antibiotics intimate directly with their bacteriostatic effects. Conversely, Bacteria can be adapted to the selective pressure from antibiotics via genetic adaptation foremost to the development of antibiotic resistance. But, at present efficiency of this conventional antibiotic treatments is declining, whereas the occurrence of multiple resistant pathogenic bacteria is increasing day by day. The antibacterial potential of plants extracts is anticipated to hindrance the process through the materialization of effective antimicrobial substances [5].
Nanotechnology is an enormous scientific advancement with profound implications in all the existing fields such as chemistry, biology, physics, material science, and engineering. The core of nanotechnology relies on the size, shape and opto-chemical properties in transforming a naive particle into a functional one [6]. There are two commonly known classical methods of synthesizing nanoparticles viz. chemical and physical method with certain limitations such as the cost, release of hazardous by-products, time-consuming and most importantly downstream processing of nanoparticles [7]. To overcome this scenario and to reduce the use of toxic and hazardous materials for synthesizing nanomaterials, green synthesis route has been employed actively across all fields of science and technology [8]. Biosynthesis of nanoparticles using bacteria, fungi, alga, and plant materials has been the most sought out alternative in material science for an eco-benign synthesis of nanomaterials [9].
Thus, Nanoparticle can also be synthesized by the biological technique which is a quite challenging concept known as “green synthesis” of the nanoparticle. Green or biological synthesis of the nanomaterial can resolve the environmental challenges such as solar energy conservation, agricultural production, catalysis [10] and biotechnological area [11]. The green synthesis method is cost-effective, easily available, eco-friendly, less toxic in nature, large-scale production and act as reducing and capping agent as compared to the chemical method which in comparison is very costly along with this it emits hazardous by-product which can have some venomous effect on the environment [12]. Green synthesis of nanoparticles utilizes naturally occupying reducing agent such as plant extract, microorganism, enzymes, a polysaccharide which are simple and viable can act as an alternative to the complex and toxic chemical processes helps to reduce the consequence of chemical methods [13]. Recently, plants and their product have been gaining importance due to their unique constituents and their versatile applicability in various developing fields of research and development for living and non-living. Plants provide a potential pathway provides a safe and beneficial way to the synthesis of the nanoparticle as compared to other existing different biological agents such as bacteria, fungi, etc. As the plants are easily accessible provides the possibilities for large-scale production and eco-friendly also [14]. Thus, Nanotechnology can be considered as an advanced and effective move toward the development of novel non-traditional antibacterial/microbial agents using plants products.
To exploit the constituents of plants various researchers have combined the research on plants with the well-established field of Nanoscience can be called as “Nanobiotechnology”. In the current situation, the Nano-biotechnology is one among the most energetic platform, explore the contemporary substantial discipline where the plants and various plant products find an imperious use in the fabrication of nanoparticles [15]. As vast applications of Nanomaterials in various fields such as electronic, magnetic, optoelectronics, and information storage are well established. They are also broadly applied in shampoos, detergents, soaps, cosmetics, toothpaste, and medical and pharmaceutical product. Researchers have found the remarkable application of Nanomaterial in the field of medicine such as antimicrobial activity. The use of nanomaterials extends in the areas of cosmetics and healthcare products, in biomedicine and as a carrier in drug delivery, in chemical industries, in optics, electronics, space industries, energy science, catalysis, single electron transistors, light emitters, nonlinear optical devices, and photo-electrochemical applications and so on [16].
The metallic nanoparticles such as copper, zinc, titanium, magnesium, gold, etc. are considered the most promising due to their remarkable antimicrobial properties. This antimicrobial property attracts the interest of researchers due to the development of resistant strains of microbes against antibiotics. Compared to other heavy metal nanoparticles, silver nanoparticles are most important because of their unique properties such as good conductivity, chemical stability, catalytic and most important antibacterial, antiviral, antifungal and anti-inflammatory activities. The green synthesis of silver nanoparticles (Ag NPs) has made a lot of mindfulness from scientific experts and analysts everywhere throughout the world. Especially, Indian greenery is yet to discover its inestimable resource of cost-effective, safe reducing and stabilizing compounds bestowed in the preparing of Ag NPs [17,18]. Silver nanoparticles have already been synthesized using various plant extracts such as Acorus calamus [19], Sesuvium portulacastrum [20], Ficus carica [21], etc. have already been reported earlier.
In our present study, we have applied the eco-friendly and convenient green method for the synthesis of silver nanoparticles from silver nitrate using the A. bilimbi leaf and P. bokharensis (Plum) fruit extracts. In the research, the plant-mediated synthesized silver nanoparticles were characterized by structural, optical and chemical characterization techniques and studied in details with all of their significant properties. The antimicrobial effects of the plant extract were evaluated by the disk diffusion method. This work is the first reported study present on the synthesis of silver nanoparticles using Plum fruit extracts and A. bilimbi leaf extract which is an additional confirmation of previous reports on the biological synthesis of silver nanoparticles using A. bilimbi leaf [22] and their antimicrobial activity.
2 Materials and methods
2.1 Plant collection and authentication
The medicinal plant Averrhoa bilimbi is shown in Figure 1 and was collected from IIT-Madras campus, Guindy, Chennai, Tamil Nadu in a sterile polyethylene bag. Morphological characteristics of the selected plant were recorded, and it was authenticated by the Chief Botanist, Tamil Nadu Medical Plant Farms and Herbal Medicine Corporation Limited (TAMPCOL) at Government Siddha Medical College, Arumbakkam, Chennai, India. Similarly, fresh fruits of Prunus bokharensis (Plum) is shown in Figure 2 and were procured from the Koyambedu Market. The morphological characters were recorded and authenticated by the Chief Botanist, TAMPCOL.

Averrhoa bilimbi.

Prunus bokharensis (Plum).
2.2 Preparation of extracts
A. bilimbi leaves and P. bokharensis fruits collected were thoroughly washed in distilled water, chopped into fine pieces and left to dry at room temperature. 100 g of dried leaves of A. bilimbi was boiled in 100 mL of distilled water in a separate flask and filtered through Whatman No. 1 filter paper. The filtrate obtained was stored at 4°C for further experimental. The Plum fruits’ seeds were blended with a mixer (50:50) to a paste-like consistency and filtered using a Whatman No.1 filter. The filtrate obtained was stored at 4°C for further experimental (Figure 3).

Formation of plant extract of Plum fruit: (a) dried seeds, (b) organic extract, (c) filtered solution (fruit extract).
2.3 Synthesis of silver nanoparticles
2.3.1 Averrhoa bilimbi leaf and Plum fruit extract
The aqueous solution of 1 mM silver nitrate (AgNO3) was prepared and used for the synthesis of silver nanoparticles. To 10 mL of aqueous plant extract of Averrhoa bilimbi leaf and Plum fruit took in two separate Erlenmeyer flasks, 90 mL of 1 mM AgNO3 was added separately under the stirring condition and kept for 20 min at 60°C. The presentation color of the mixture in two separate flasks was observed for any color change upon reduction [23].
2.4 Characterization of silver nanoparticles
Due to the reduction of Ag+ ions, the visual change in color was observed upon heating and cultivation of the reaction mixture. UV–Vis Spectra (Shimadzu-1800) was measured in the range of 200-800 nm. The X-ray diffractometer (XPERT-PRO) using Cu-Kα radiation of wavelength λ = 1.541 Å was used to find the crystallite size and phase purity. The FTIR spectra were recorded using JASCO FT/IR 4600 in the range of 4000-400 cm-1 to confirm the functional groups present. The surface morphology was analyzed by Field emission scanning electron microscopy (FESEM, Supra-55, India) and the elemental composition identification was recorded using EDX, BRUKER, India. Dynamic light scattering (DLS was employed to study the average particle size by DelsaNano C instrument (Beckman Coulter).
2.5 In vitro cytotoxicity study
2.5.1 Cell line maintenance and growth conditions
Vero (African green monkey kidney epithelial cells) and Hep-2 (Human epidermoid larynx carcinoma) cell lines were procured from NCCS, Pune, India. Cells were examined for confluency and contamination and retained for further experimental by incubating at 37°C with 5% CO2.
2.5.2 Cytotoxicity assay – MTT method
Vero and HEp-2 cells were cultured in 96 well microplates (1x105 cells/well) in 10% FBS incorporated DMEM medium for 18 h and then incubated with different concentrations of samples (500, 250, 125, 62.5, 31.25, 15.625 μg/mL). The control well was made with cells inoculated in 100 mL of the medium. The plate was incubated at 37°C in a CO2 incubator for 24 h. After incubation 10 μL of MTT (5 mg/mL) solution was added to each well and incubated for 4 h. The formazan crystals formed was solubilized in 100 μL of DMSO and the OD was recorded at 540 nm in an ELISA plate reader. The % viability of cells was calculated using the formulae:
2.5.3 Statistical analysis
The experiment was performed in triplicates and all the data articulated as the mean ± standard error of the mean. The outcomes were subjected to Student’s t-test and calculated statistically significant if the p-value ≤ 0.05.
3 Results and discussion
3.1 Biosynthesis of silver nanoparticles
The extract of Averrhoa bilimbi leaf and Plum fruit were mixed and incubated with AgNO3 solution, change in color of the solution from pale green to dark brown indicated the visible reduction of leaf and fruit extracts arbitrated synthesis of AgNPs. The reaction mixture of Plum fruit extract after 20 min of reaction is shown in Figure 4. The color change designated the transformation to AgNPs. Whereas when the two mixtures were heated separately at 60°C for 20 min, the color change was more prominent than compared to change occurring at room temperature. After the heat treatment, the mixtures could cool normally at room temperature to complete the reduction process. It was observed that the reduction was completed within 24 h since no further color change was observed indicating the complete reduction to AgNPs. This reduction of the metal ions occurs fairly rapidly; more than 90% of reduction of Ag+ ions completes within 10 min after the addition of the metal ions to plant extract. The expected color change in AgNPs in water is due to Surface Plasmon Resonance (SPR) [24,25] arising due to the upward transition of free electrons in AgNPs giving rise to the SPR absorption band because of the resonance of AgNPs with the light wave [26]. Similar results have also been reported in Earlier studies on the synthesis of AgNPs synthesized by A. bilimbi leaf extract also report similar outcomes thus confirming the complete transformation of and AgNO3 to AgNPs using Averrhoa bilimbi leaf and Plum fruit extracts [22]. The metal particles were observed to be stable even 2 months after synthesis. The particles were found to be suspended uniformly with no aggregation exhibiting the same absorption. Control experiments performed without the addition of plant extracts exhibits no transformation of color, demonstrating the color change was entirely due to the occurrence of plant extracts present in the silver nitrate solution [27].

Synthesis of silver nanoparticles synthesis by Plum fruit extract.
3.2 UV-Vis spectrophotometer analysis
The reduction of silver nitrate into silver nanoparticles using the plant extract of A. bilimbi leaf and Plum fruit was observed by the change in color of the colloidal solution as shown in Figure 4. The absorbance spectra of Ag NPs at various time intervals were recorded using UV-vis spectrophotometer as in Figures 5a and 5b In both the cases, the spectrum shows an intense peak at 450 nm for A. bilimbi and 405 nm for Plum fruit respectively with typical surface plasmon resonance (SPR) for Ag NPs. The SPR corresponds to the aggregation of conduction electrons in a metal. Also, the absorption spectrum of Ag NPs can be attributed to the property of Mie scattering resonance [28,29].

UV-Vis absorption spectra of Ag NPs of (a) A. bilimbi leaf and (b) Plum fruit.
3.3 X-ray diffraction
Analysis of physical structure and crystallite size of the phytochemical mediated synthesis of silver nanoparticles was determined from the using X-ray diffraction pattern (XRD). The typical XRD pattern of synthesized silver nanoparticles using a leaf extract of A. bilimbi and fruit extract of Plum is shown in Figures 6a and 6b, respectively. A. bilimbi leaf extract and Plum fruit mediated synthesis showed the same diffraction peaks at 2θ = 32.04°, 35.67°, 44.52°, 61.65°, and 75.23° corresponding to (104), (111), (200), (300) and (311) that can be assigned to face centered cubic symmetry of a silver crystal [30,31]. These characteristics were compared to standard powder diffraction card of Joint Committee on Powder Diffraction Standards that corroborated with JCPDS (No. 84-0713) [32]. The Debye-Scherer equation was used to calculate the crystallite size of AgNP as in Eq. 2:

X-ray diffraction pattern of AgNPs (JCPDS No: 84-0713) of (a) A. bilimbi leaf and (b) Plum fruit.
where D indicates the size of the NP, K is a constant ranging from 0.9 to 1.0, λ is the X-ray wavelength (1.5418 Å), β is the line broadening at half the maximum intensity (FWHM); θ is the Bragg angle (in degrees) [33].
The average size of the synthesized silver nanoparticles from a plant extract of A. bilimbi leaf and Plum fruit were found to be 29 nm and 47 nm, respectively. Bragg’s peaks get broaden around their bases shown in Figures 6a and 6b indicating the formation of small sized silver nanoparticles [34]. These Bragg peaks might have resulted from bioorganic compounds/ proteins present in the Plum fruit extract which crystallizes at the surface of the silver [35].
3.4 Fourier transform infra-red spectroscopy
The potential functional groups responsible for the biosynthesis of Ag NPs from leaf and fruit extract of A. bilimbi and Plum were identified by FTIR analyses shown in Figure 7a and 7c respectively in comparison with FTIR spectrum of AgNPs shown in Figure 7b The phytochemical compounds behaved as a reducing and stabilizing agent as well in the synthesis [36]. The FTIR spectrum of silver nanoparticles synthesized using A. bilimbi leaf extract, Figure 7a shows the prominent absorption peaks at 3450 cm-1, 2073 cm-1, 1636 cm-1, and 648 cm-1 indicating the presence of N-H asymmetric stretching attributing to Amides group, C=C stretching vibration indicating Alkynes group, N-H bend indicating the primary Amines group and C-Br stretching vibration indicating the Alkyl halides group. FTIR spectroscopic studies confirmed that a peak residing at 655 cm-1 specified strong binding affinities with the metal suggesting the encapsulation of metal nanoparticles. These results confirm the presence of possible proteins acting as reducing and stabilizing agents for Silver Nanoparticles [37]. The FTIR spectrum of AgNPs synthesized using Plum fruit extract is shown in Figure 7c The Sharp absorption peak at 664 cm-1 can be attributed due to C–Cl stretching for halogen compounds, the alcohol and phenols stretching of C–O bond occur at 1072 cm-1, the band at 1612 cm-1 exist due to C=O stretch of tertiary amides and the broad peak at 3424 cm-1 is the characteristic O–H stretching for alcohols and phenols. Also, the carbonyl group present in amino acid debris and proteins showcase a stronger possibility to interact with metal for a possible capping, thereby avoiding agglomeration. Thus, biological molecules enforce the dual role of formation and stabilization of AgNPs in the aqueous medium [38].

FTIR spectra of synthesized silver nanoparticles using (a) A. bilimbi leaf extract, (b) silver nanoparticle, (c) Plum fruit extract.
3.5 Field emission scanning electron microscope (FESEM)
Surface Morphology, size, and shape of the synthesized silver nanoparticles by using plant extract of Averrhoa bilimbi leaf and Plum fruit analyzed by FESEM showed in Figure 8. Images of the silver nanoparticles synthesized by Averrhoa bilimbi leaf extract is shown in Figure 8a and 8b The surface morphology of silver oxide nanoparticles showed even shape and spherical nature. In the present study, the histogram of the particle size ranges from 20 to 50 nm. Figure 8c and 8d shows the FESEM images of the synthesized silver nanoparticles by using Plum fruit extract. From the figure, it is clear that spherical particles are predominating with an almost smooth surface that is closely packed. The average particle size was found around 47 nm. The dimension observed here is approximately the same as the crystallite size as inferred by XRD. Thus, the outcomes strongly recommend that Averrhoa bilimbi leaf extract acts as a strong reducing and capping agent in the assembling of silver nanoparticles [39].

FESEM image of silver nanoparticles synthesized from Plum fruit extract.
3.6 Energy dispersive X-ray (EDS) analysis
An X-ray EDS analysis was performed to authenticate the presence of AgNPs using A. bilimbi leaf and Plum fruit, shown in Figures 9a-d Due to the existence of Surface Plasmon Resonance, typically strong resonance peak was observed at 3 keV for AgNPs obtained from both extracts [40]. Also, weak peaks for Carbon and Oxygen was also reflected in the EDS analysis. The existence of the frail oxygen peak can be predicted due to the discharge of carbohydrates or protein enzymes present within the plant extracts during X-ray emission [41]. Since, the nanoparticles formed are highly reactive due to their elevated surface to volume ratio, during the reduction process the probability of formation of silver oxide nanoparticles is also evidence of its reactivity with an aqueous solution, which can be considered as one of the benefits of green synthesis of NPs over conventional methods [42]. In the current examination, the AgNPs confirms a stronger absorption in the range between 1.261 and 1.721 keV. The weight of the atomic percentage of the reduced AgNPs has been represented in Table 1.

EDS image of synthesized silver nanoparticles from: (a,b) Averroh bilimbi leaf extract, (c,d) Plum fruit extract.
EDS Atomic percentage of formation of silver nanoparticles.
Element | Weight% | Atomic% |
---|---|---|
O K | 42.02 | 83.01 |
Ag L | 57.98 | 16.99 |
Totals | 100.00 |
3.7 Dynamic light scattering (DLS) analysis
DLS was used to investigate the particle size of the synthesized AgNPs by means of A. bilimbi leaf and Plum fruit extract. Figure 10a shows the DLS graph of A. bilimbi leaf and Plum fruit extract respectively. The polydispersity index (PDI) of particles in a colloidal suspension is determined by the graphs shown in Figures 10a and 10b The mean size of silver nanoparticles synthesis by leaf extract at optimum condition was recorded 160 nm and the range of nanoparticles from 1.6 to 160 nm. Figure 10b displays the DLS chart of Plum fruit extract. Grounded on the observed results mean size of silver nanoparticles was recorded as 128 nm and spread in the range from 1.7 to 137 nm. A for The PDI is a measurement of the dispersed silver nanoparticle was in the range from 0.001 to 0.5 if PDI is larger than 0.5, it indicates the aggregation of particles [43]. Thus, the synthesized silver nanoparticle by Averroh bilimbi leaf and Plum fruit extracts does not aggregate. As predicted from FESEM and XRD studies, the DLS measured the size of the particles is somewhat bigger for both the extracts.

DLS analysis of synthesized silver nanoparticle obtained from: (a) Averrhoa bilimbi leaf extract, (b) Plum fruit extract.
3.8 Antimicrobial susceptibility testing-well diffusion assay
The antibacterial activity of the Ag NPs synthesized using A. bilimbi leaf and Plum fruit extracts were determined by agar disk diffusion method against pathogenic bacteria such as Staphylococcus aureus, Escherichia coli, Pseudomonas aeruginosa, and Salmonella typhi. Ag NPs (synthesized from two different extracts) of concentrations 2, 4 and 6 mg/mL was prepared in MilliQ water and added to the wells of lawn cultured agar plates. The aqueous extract served as negative control and Amoxicillin antibiotic served as a positive control. The plates were incubated at 37°C for 18-24 h in a humidified chamber. The antimicrobial susceptibility of Ag NPs as shown in Figures 11 and 12 revealed significant inhibition in a concentration-dependent fashion against Escherichia coli, Staphylococcus aureus, Pseudomonas aeruginosa, and Salmonella typhi. There was a maximum inhibition in the growth of S. typhi with 70%, 77.5% and 85% inhibition at 2, 4 and 6 mg/mL concentrations. This was followed by P. aeruginosa with 66.6%, 71.4% and 78.5% and E. coli with 63.1%, 71% and 78.9% at given concentrations. These results agreed with the earlier reports on the susceptibility patterns [44]. On the other hand, the susceptibility pattern varied with Gram-positive bacterium viz. S. aureus with 57.8%, 65.7%, 68.4% at 2, 4 and 6 mg/mL concentration of Ag NPs. Among the bacterial strains exposed, Gram-negative strains showed higher susceptibility towards Ag NPs as evidenced from the zone of inhibition which is mainly due to the discrepancy in the composition of cell wall exist between the gram positive and gram negative bacteria [27]. The difference in inhibition toward different strains was found to be statistically significant (ANOVA, p < 0.05).

Antibacterial activity of A. bilimbi leaf extract mediated synthesized AgNPs: (a) Escherichia coli, (b) Staphylococcus aureus, (c) Pseudomonas aeruginosa and (d) Salmonella typhi.

Antimicrobial activity of Ag NPs synthesized by A. bilimbi leaf extract represented in %.
Similarly, the antimicrobial susceptibility of Ag NPs synthesized using Plum fruit extract was elaborated in Figures 13 and 14 revealing significant inhibition in a concentration-dependent fashion against the test cultures. There was a maximum inhibition in the growth of S. typhi with 75%, 82.5% and 90% inhibition at 2, 4 and 6 mg/mL concentrations. This was followed by P. aeruginosa with 71.4%, 78.6%, 85.7% and E. coli with 68.4%, 76.3% and 84.2% at all concentrations. The susceptibility pattern followed the same trend as A. bilimbi leaf toward Gram-positive S. aureus with 63.2%, 71.1% and 78.9% at 2, 4 and 6 mg/mL concentrations [45]. Moreover, statistical analysis across different groups of test organisms exposed to different doses was found significant (ANOVA, p < 0.05)
Antibacterial activity of Plum fruit extract mediated synthesized AgNPs: (a) Escherichia coli, (b) Staphylococcus aureus, (c) Pseudomonas aeruginosa and (d) Salmonella typhi.

Antimicrobial susceptibility of Ag NPs synthesized by Plum fruit extract represented in %.
This severity might have resulted due to the membranous architecture present in Gram-negative strains. The absence of thick peptidoglycan in Gram-negative strains might have paved way for nanoparticles intrusion and ionization pertinent to severe damage in the cell membrane. On the other hand, the presence of peptidoglycan in Gram-positive strain could have trapped most of the nanoparticles thereby preventing the cells from damage [46]. The nanoparticles preferably attack the respiratory chain and cell division finally leading to cell death.
The synthesized Ag NPs using A. bilimbi leaf and Plum fruit extracts shows highest antibacterial activity against S. typhi followed by P. aeruginosa in both the cases. Moreover, the synthesized AgNPs enhance the remedial adequacy of both the extracts when consolidating with silver.
3.9 In vitro cytotoxicity study of Vero and HEp-2 cells
The anti-proliferative activity of phytochemical mediated synthesis of Ag NPs was investigated for their cytotoxicity in Vero and Human epidermoid larynx carcinoma cell lines (HEp-2) based on their viability using MTT assay. As shown in Figure 15, Vero and HEp-2 cells exposed to Ag NPs were read after 24 h of treatment. There was a significant cytotoxic effect in a concentration-dependent manner. The estimated half maximal inhibitory concentration (IC50) for A. bilimbi mediated Ag NPs exposed to Vero and HEp-2 cells was determined to be 76.9 μg/mL and 49.49 μg/mL respectively. Similarly, the IC50 for Plum fruit extract mediated Ag NPs exposed worked out to 74.4 μg/mL and 62.5 μg/mL for Vero and HEp-2 cells respectively. The estimated MIC values carry critical consequence as low MIC indicates well-built bioefficacy of the extracts [47]. The MIC result showed that increasing concentration has increased efficiency in inhibiting the organisms used. Since more MIC values of Plum fruit extract indicate its more discrete nature of the antimicrobial activities as compared to A. bilimbi.

Cytotoxicity studies on Vero and HEp2 cells exposed to Ag NPs synthesized using (a) A. bilimbi leaf extract and (b) Plum fruit extract.
The cytotoxic effects were characterized from rounding of cells, clumping up of cells and non-adherence to the well surface at higher concentrations as in Figure 16. The increased cytotoxicity toward HEp-2 cells (carcinoma cells) was induced by Ag NPS synthesized using A. bilimbi leaf extract. This probably suggests the role of phytochemical compounds such as phenols, triterpenoids, and flavonoids acting synergistically with the nanoparticles in the event of inducing cytotoxicity. Alongside, there was also an enhancement in the diffusion of nanoparticles into the cell membrane by the greater intracellular uptake of the positively charged Ag NPs with non-specific interaction with the negatively charged cell membrane.

Micrograph of cytotoxicity induced by Ag NPs on Vero and HEp2 cells. Vero: control (a,e), IC50 of A. bilimbi Ag NPs (b) and IC50 of Plum Ag NPs (f). HEp2: control (c,g), IC50 of A. bilimbi Agnps (d) and IC50 of Plum Ag NPs (h).
The detected IC50 value for A. bilimbi mediated Ag NPs exposed to Vero and HEp-2 cells was determined to be 76.9 μg/mL and 49.49 μg/mL respectively. IC50 for Plum fruit extract mediated Ag NPs exposed worked out to 74.4 μg/mL and 62.5 μg/mL for Vero and HEp-2 cells. Data are expressed as Mean ± SD of three experiments. Percentage of cytotoxicity relative to controls (*p < 0.05).
The transport of Ag NPs inside the cell begins with receptor recognition, internalization, and translocation. Once the Ag NPs were in-taken via endocytosis, the major target organelles were endosomes and lysosomes [48]. Internalized Ag NPs were found in mitochondria and the nucleus. Once internalized, these Ag NPs induce a series of effects including oxidative stress, impairment of the cell membrane, cell cycle arrest, inflammatory responses, DNA damage and genotoxicity, chromosome aberration and apoptosis [49]. Moreover, these Ag NPs have the capacity to produce ROS and oxidative stress by themselves imparting toxic effects on the cells thereby influencing cellular responses [50].
4 Conclusion
Cost-effective, safe, non–toxic, economical and environmentally friendly silver nanoparticles (Ag NPs) were successfully synthesized using the leaf and fruit extract of A. bilimbi and Plum plant. Phytochemical moieties present in the leaf and fruit extracts played a major role as a reducing and capping agent. Biosynthesis of silver oxide nanoparticle was firstly visible confirmed by the change in color of the solution from pale green to dark brown. The surface plasmon vibrations present in silver nanoparticles responsible for the yellowish brown color in water which is further confirmed by UV-Vis Spectrophotometer Analysis shows sharp bands obtained at the peak range of 450 nm and 405 nm of synthesized silver nanoparticles from extracts of A. bilimbi leaf and Plum fruit respect. The XRD patterns confirmed the purity, face-centered cubic and crystalline nature of the synthesized silver nanoparticles by using A. bilimbi leaf and Plum fruit extracts with size ranging between 29 nm and 47 nm, respectively. FTIR analysis unraveled the presence of phytochemical moieties involved in the reduction process and capping agent as well as present in the extract solution. FESEM and EDS analysis were helpful at deciphering their morphology spherical in shape and stable were also in full agreement with the XRD results obtained. The particle size distribution recorded for silver nanoparticles by DLS analysis in the range from 1.6 to 160 nm and 1.7 to 137 nm for Averrhoa bilimbi leaf and Plum fruit resp.
Ag NPs synthesized using leaf extract of A. bilimbi showed significant antibacterial activity against the tested pathogens than Plum fruit extract. Gram-negative strains sustained severe damage than Gram-positive strains due to the membranous architecture. Alongside, Ag NPs synthesized using leaf extract of A. bilimbi showed significant cytotoxicity toward HEp-2 cells with an IC50 value of 49.49 μg/mL on a par with Vero cells. This synergistic antimicrobial and cytotoxic effect induced by plant-mediated synthesis protocol might open new vistas in the field of nanomedicine once the level of toxicity in vivo is validated.
Competing interests:
The authors declare no conflict of interest.
Acknowledgments
The author would like to acknowledge the financial support provided by Research University grant number (RU001-2018) NANOCAT, University of Malaya, Malaysia. One of the authors (Suresh Sagadevan) acknowledges the honor, namely the “Senior Research Fellow” at Nanotechnology & Catalysis Research Centre (NANOCAT), University of Malaya 50603 Kuala Lumpur, Malaysia. The author wishes to place on record his heartfelt thanks that are due to the authorities concerned.
References
[1] Ansari M.A., Khan H.M., Khan A.A., Cameotra S.S., Pal R., Antibiofilm efficacy of silver nanoparticles against biofilm of extended spectrum b-lactamase isolates of Escherichia coli and Klebsiella pneumoniae Appl. Nanosci, 2013, 7, 859-868.10.1007/s13204-013-0266-1Search in Google Scholar
[2] Jyothi A., Manjunath C., Chandrakanth R.K., Prevention of multiple drug resistant bacterial biofilm by synergistic action of biogenic silver nanoparticle and antimicrobials. J. Microbial. Biotech. Res., 2015, 5, 14-21.Search in Google Scholar
[3] Donlan R.M., Biofilms and device-associated infections. Emerg. Infect. Dis., 2001, 7, 277-281.10.3201/eid0702.010226Search in Google Scholar PubMed PubMed Central
[4] Markowska K., Grudniak A., Wolska K., Silver nanoparticle as an alternative strategy against bacterial biofilms. Acta Biochimi. Pol., 2013, 60, 523-530.10.18388/abp.2013_2016Search in Google Scholar
[5] Satish S., Raghavendra M.P., Raveesha K.A., Evaluation of the Antibacterial Potential of Some Plants Against Human Pathogenic Bacteria. Advances in Biological Research, 2008, 2(3-4), 44-48.Search in Google Scholar
[6] Shet A.R., Ghose P., Patil L., Hombalimath V., A preliminary study on green synthesis and antibacterial activity of silver nanoparticles. Int. J. Curr. Biotechnol., 2015, 3, 1-6.Search in Google Scholar
[7] Nagajyothi P.C., Lee K.D., Synthesis of Plant-Mediated Silver Nanoparticles Using Dioscorea batatas Rhizome Extract and Evaluation of Their Antimicrobial Activities. J. Nanomater., 2011, 573429, 1-7.10.1155/2011/573429Search in Google Scholar
[8] Ahmad N., Sharma S., Singh V.N., Shamsi S.F., Fatma A., Mehta B.R., Biosynthesis of Silver Nanoparticles from Desmodium triflorum A novel approach towards weed utilization. Biotechnol. Res. Inter., 2011, 454090, 1-8.10.4061/2011/454090Search in Google Scholar PubMed PubMed Central
[9] Kulkarni N., Muddapur U., Biosynthesis of Metal Nanoparticles: A Review. J. Nanotechnol., 2014, 510246, 1-8.10.1155/2014/510246Search in Google Scholar
[10] Kumar B., Naik V., Halehatty S.B., Girija D., Kumar B.V., ZnO nanoparticle as catalyst for efficient green one-pot synthesis of coumarins through Knoevenagel condensation. J. Chem. Sci., 2011, 123, 615-621.10.1007/s12039-011-0133-0Search in Google Scholar
[11] Soloviev M., Nanobiotechnology today: focus on nanoparticles. J. Nanobiotechnol., 2007, 5, 1-11.10.1186/1477-3155-5-11Search in Google Scholar PubMed PubMed Central
[12] Pramila M., Meenakshisundaram M., Biosynthesis of Iron (Fe) Nanoparticles And Its Inhibitory Effect On Pseudomonas Aeruginosa Biofilm. Indian J. App. Res., 2017, 7, 251-524.Search in Google Scholar
[13] Das R.K., Pachapur V.L., Lonappa L., Naghdi M., Pulicharla R., Maiti S., et al., Biological synthesis of metallic nanoparticles: plants, animals and microbial aspects. Nanotechnol. Environ. Eng., 2017, 18, 1-21.10.1007/s41204-017-0029-4Search in Google Scholar
[14] Nair R., Varghese S.H., Nair B.G., Maekawa T., Yoshida Y., Kumar S.D., Nanoparticulate material delivery to plants. Plant Sci., 2010, 179, 154-163.10.1016/j.plantsci.2010.04.012Search in Google Scholar
[15] Wildenberg V.D., Roadmap report on nanoparticles. W&W Espana sl, Barcelona, Spain, 2005.Search in Google Scholar
[16] Quang H.T., Van Q.N., Anh-Tuan L., Silver nanoparticles: synthesis, properties, toxicology, applications and perspectives. Adv. Nat. Sci. Nanosci. Nanotechnol., 2013, 4, 1-20.10.1088/2043-6262/4/3/033001Search in Google Scholar
[17] Khalil K.A., Fouad H., Elsarnagawy T., Almajhdi F.N., Preparation and characterization of electrospun PLGA/silver composite nanofibers for biomedical applications. Inter. J. Electrochem. Sci., 2013, 8, 3483-3493.Search in Google Scholar
[18] Ahmad A., Mukherjee P., Senapati S., Extracellular biosynthesis of silver nanoparticles using the fungus Fusarium oxysporum Colloid. Surface. B, 2003, 28, 313-318.10.1016/S0927-7765(02)00174-1Search in Google Scholar
[19] Nakkala J.R., Mata R., Gupta A.K., Sadras S.R., Biological activities of green silver nanoparticles synthesized with Acorous calamus rhizome extract. Eur. J. Med. Chem., 2014, 8, 784-794.10.1016/j.ejmech.2014.08.024Search in Google Scholar PubMed
[20] Nabikhan A., Kandasamy K., Raj A., Alikunhi N.M., Synthesis of antimicrobial silver nanoparticles by callus and leaf extracts from saltmarsh plant Sesuvium portulacastrum L, Colloid. Surface. B, 2010, 79, 488-493.10.1016/j.colsurfb.2010.05.018Search in Google Scholar PubMed
[21] Ulug B., Turkdemir M.H., Cicek A., Mete A., Role of irradiation in the green synthesis of silver nanoparticles. Spectrochim. Acta A, 2015, 135, 153-161.10.1016/j.saa.2014.06.142Search in Google Scholar PubMed
[22] Isaac R.S.R., Sakthivel G., Murthy C.H., Green Synthesis of Gold and Silver Nanoparticles Using Averrhoa bilimbi Fruit Extract. J. Nanotechnol., 2013, 906592, 1-6.10.1155/2013/906592Search in Google Scholar
[23] Singh K., Panghal M., Kadyan S., Yadav J.P., Green silver nanoparticles of Phyllanthus amarus as an antibacterial agent against multi drug resistant clinical isolates of Pseudomonas aeruginosa J. Nanobiotechnol., 2014, 12(40), 1-9.10.1186/s12951-014-0040-xSearch in Google Scholar PubMed PubMed Central
[24] Veeraputhiran V., Bio-Catalytic synthesis of silver nanoparticles. Inter. J. Chemtech. Res., 2013, 5, 2555-2562.Search in Google Scholar
[25] Sadeghi B., Rostami A., Momeni S.S., Facile green synthesis of silver nanoparticles using seed aqueous extract of Pistacia atlantica and its antibacterial activity. Spectrochim. Acta A, 2015, 134, 326-332.10.1016/j.saa.2014.05.078Search in Google Scholar PubMed
[26] Roy K., Biswas S., Banerjee P.C., Green synthesis of silver nanoparticles by using grape Vitis vinifera fruit extract: Characterization of the particles and study of antibacterial activity. Res. J. Pharma. Bio. Chem. Sci., 2013, 4, 1271-1278.Search in Google Scholar
[27] Jemal K., Sandeep B.V., Pola S., Synthesis, Characterization, and Evaluation of the Antibacterial Activity of Allophylus serratus Leaf and Leaf Derived Callus Extracts Mediated Silver Nanoparticle. J. Nanomater., 2017, 4213275, 1-11.10.1155/2017/4213275Search in Google Scholar
[28] Sileikaite A., Prosycevas I., Puiso J., Juraitis A., Guobiene A., Analysis of Silver Nanoparticles Produced by Chemical Reduction of Silver Salt Solution. Mat. Sci., 2006, 12, 287-291.Search in Google Scholar
[29] Aoki K., Chen J., Yang N., Nagasaga H., Charge-Transfer Reactions of Silver Stearate-Coated Nanoparticles in Suspensions. Langmuir, 2003, 19, 9904-9909.10.1021/la035144gSearch in Google Scholar
[30] Roy K., Sarkar C.K., Ghosh C.K., Plant-mediated synthesis of silver nanoparticles using parsley Petroselinum crispum leaf extract: spectral analysis of the particles and antibacterial study. App. Nanosci., 2015, 5, 945-951.10.1007/s13204-014-0393-3Search in Google Scholar
[31] Chandrasekaran C.V., Sundarajan K., Edwin J.R., Gururaja G.M., Mundkinajeddu D., Agarwal A., Immune-stimulatory and anti-inflammatory activities of Curcuma longa extract and its polysaccharide fraction. Pharmacogn. Res., 2013, 5, 71-79.10.4103/0974-8490.110527Search in Google Scholar PubMed PubMed Central
[32] Elumalai D., Hemavathi M., Deepa C.V., Kaleen P.K., Evaluation of photosynthesized silver nanoparticles from leaf extracts of Leucas aspera and Hyptis suaveolens and their larvicidal activity against malaria, dengue and filariasis vectors. Parasite Epidemiol. Control, 2017, 18, 15-26.10.1016/j.parepi.2017.09.001Search in Google Scholar PubMed PubMed Central
[33] Pradeev raj K., Sadaiyandi K., Kennedy A., Sagadevan S., Chowdhury Z.Z., Bin Johan M.R., et al., Influence of Mg Doping on ZnO Nanoparticles for Enhanced Photocatalytic Evaluation and Antibacterial Analysis. Nanoscale Res. Lett., 2018, 13, 229.10.1186/s11671-018-2643-xSearch in Google Scholar PubMed PubMed Central
[34] Annadurai G., Gnana Jobith G., Rajeshkumar S., Kannan C., Preparation and characterization of fruit-mediated silver nanoparticles using pomegranate extract and assessment of its antimicrobial activities. J. Env. Nanotechnol., 2013, 2, 4-10.10.13074/jent.2013.02.121023Search in Google Scholar
[35] Philip D., Mangifera indica leaf-assisted biosynthesis of well dispersed silver nanoparticles. Spectrochim. Acta A., 2011, 78, 327-331.10.1016/j.saa.2010.10.015Search in Google Scholar PubMed
[36] Jesús A.D., Baltazar R., Yobbany S., Lopez R., Larranaga D., Estevez M., et al., Green synthesis of silver nanoparticles using a Melissa officinalis leaf extract with antibacterial properties. Results Phys., 2017, 7, 2639-2643.10.1016/j.rinp.2017.07.044Search in Google Scholar
[37] Huang Q., Li D., Sun Y., Lu Y., Su X., Yang H., et al., Biosynthesis of silver and gold nanoparticles by novel sundried Cinnamomum camphora leaf. Nanotechnol., 2007, 18, 105104.10.1088/0957-4484/18/10/105104Search in Google Scholar
[38] Selvaraj V., Sagadevan S., Muthukrishnan L., Johan M.R., Podder J., Eco-friendly approach in synthesis of silver nanoparticles and evaluation of optical, surface morphological and antimicrobial properties. J. Nan. Chem., 2019, DOI:10.1007/s40097-019-0306-9.10.1007/s40097-019-0306-9Search in Google Scholar
[39] Banerjee P., Satapathy M., Mukhopahayay A., Das P., Leaf extract mediated green synthesis of silver nanoparticles from widely available Indian plants: synthesis, characterization, antimicrobial property and toxicity analysis. Bioresources and Bioprocessing, 2014, 1, 1-10.10.1186/s40643-014-0003-ySearch in Google Scholar
[40] Bindhu M.R., Umadevi M., Synthesis of monodispersed silver nanoparticles using Hibiscus cannabinus leaf extract and its antimicrobial activity. Spectrochim. Acta A, 2013, 101, 184-190.10.1016/j.saa.2012.09.031Search in Google Scholar PubMed
[41] Vanaja M., Annadurai G., Coleus aromaticus leaf extract mediated synthesis of silver nanoparticles and its bactericidal activity. App. Nanosci., 2013, 3, 217-223.10.1007/s13204-012-0121-9Search in Google Scholar
[42] Singha S., Neog K., Kalita P.P., Talukdar N., Sarma M.P., Biological synthesis of silver nanoparticles by Neptunia oleraceae Inter. J. Basic App. Bio., 2014, 2, 55-59.Search in Google Scholar
[43] Singh K., Panghal M., Kadyan S., Yadav J.P., Evaluation of Antimicrobial Activity of Synthesized Silver Nanoparticles using Phyllanthus amarus and Tinospora cordifolia Medicinal Plants. Nanomed. Nanotechnol., 2014, 5, 1-5.10.4172/2157-7439.1000250Search in Google Scholar
[44] Namratha N., Monica P.V., Synthesis of silver nanoparticles using Azadirachta indica (Neem) extract and usage in water purification. Asian J. Pharm. Tech., 2013, 3, 170-174.Search in Google Scholar
[45] Logeswari P., Silambarasan S., Abraham J., Synthesis of silver nanoparticles using plants extract and analysis of their antimicrobial property. J. Saudi Chem. Soc., 2015, 19, 311-317.10.1016/j.jscs.2012.04.007Search in Google Scholar
[46] Sondi I., Salopek-Sondi B., Silver nanoparticles as antimicrobial agent: a case study on E. coli as a model for Gram-negative bacteria. J. Colloid. Interface. Sci 2004, 275, 177-182.10.1016/j.jcis.2004.02.012Search in Google Scholar PubMed
[47] Sharma J., Kumar P., Comparative Study of Antimicrobial Activity and Phytochemical Screening of Serial Extracts From Leaves And Fruit of Aegle Marmelos and Carica Papaya Inter. J. Pharm. Pharm. Sci., 2017, 9, 119-123.10.22159/ijpps.2017v9i12.20228Search in Google Scholar
[48] Asharani P.V., Hande M.P., Valiyaveettil S., Anti-proliferative activity of silver nanoparticles. BMC Cell Biol., 2009, 10, 65-69.10.1186/1471-2121-10-65Search in Google Scholar PubMed PubMed Central
[49] Kim Y.J., Yang S.I., Ryu J.C., Cytotoxicity and genotoxicity of nano-silver in mammalian cell lines. Mol. Cell Toxicol., 2010, 6, 119-125.10.1007/s13273-010-0018-1Search in Google Scholar
[50] Kawata K., Osawa M., Okabe S., In vitro toxicity of silver nanoparticles at noncytotoxic doses to HepG2 human hepatoma cells. Environ. Sci. Technol., 2009, 43, 6046-6051.10.1021/es900754qSearch in Google Scholar PubMed
© 2019 Sagadevan et al., published by De Gruyter
This work is licensed under the Creative Commons Attribution 4.0 Public License.
Articles in the same Issue
- Regular Articles
- Studies on the preparation and properties of biodegradable polyester from soybean oil
- Flow-mode biodiesel production from palm oil using a pressurized microwave reactor
- Reduction of free fatty acids in waste oil for biodiesel production by glycerolysis: investigation and optimization of process parameters
- Saccharin: a cheap and mild acidic agent for the synthesis of azo dyes via telescoped dediazotization
- Optimization of lipase-catalyzed synthesis of polyethylene glycol stearate in a solvent-free system
- Green synthesis of iron oxide nanoparticles using Platanus orientalis leaf extract for antifungal activity
- Ultrasound assisted chemical activation of peanut husk for copper removal
- Room temperature silanization of Fe3O4 for the preparation of phenyl functionalized magnetic adsorbent for dispersive solid phase extraction for the extraction of phthalates in water
- Evaluation of the saponin green extraction from Ziziphus spina-christi leaves using hydrothermal, microwave and Bain-Marie water bath heating methods
- Oxidation of dibenzothiophene using the heterogeneous catalyst of tungsten-based carbon nanotubes
- Calcined sodium silicate as an efficient and benign heterogeneous catalyst for the transesterification of natural lecithin to L-α-glycerophosphocholine
- Synergistic effect between CO2 and H2O2 on ethylbenzene oxidation catalyzed by carbon supported heteropolyanion catalysts
- Hydrocyanation of 2-arylmethyleneindan-1,3-diones using potassium hexacyanoferrate(II) as a nontoxic cyanating agent
- Green synthesis of hydratropic aldehyde from α-methylstyrene catalyzed by Al2O3-supported metal phthalocyanines
- Environmentally benign chemical recycling of polycarbonate wastes: comparison of micro- and nano-TiO2 solid support efficiencies
- Medicago polymorpha-mediated antibacterial silver nanoparticles in the reduction of methyl orange
- Production of value-added chemicals from esterification of waste glycerol over MCM-41 supported catalysts
- Green synthesis of zerovalent copper nanoparticles for efficient reduction of toxic azo dyes congo red and methyl orange
- Optimization of the biological synthesis of silver nanoparticles using Penicillium oxalicum GRS-1 and their antimicrobial effects against common food-borne pathogens
- Optimization of submerged fermentation conditions to overproduce bioethanol using two industrial and traditional Saccharomyces cerevisiae strains
- Extraction of In3+ and Fe3+ from sulfate solutions by using a 3D-printed “Y”-shaped microreactor
- Foliar-mediated Ag:ZnO nanophotocatalysts: green synthesis, characterization, pollutants degradation, and in vitro biocidal activity
- Green cyclic acetals production by glycerol etherification reaction with benzaldehyde using cationic acidic resin
- Biosynthesis, characterization and antimicrobial activities assessment of fabricated selenium nanoparticles using Pelargonium zonale leaf extract
- Synthesis of high surface area magnesia by using walnut shell as a template
- Controllable biosynthesis of silver nanoparticles using actinobacterial strains
- Green vegetation: a promising source of color dyes
- Mechano-chemical synthesis of ammonia and acetic acid from inorganic materials in water
- Green synthesis and structural characterization of novel N1-substituted 3,4-dihydropyrimidin-2(1H)-ones
- Biodiesel production from cotton oil using heterogeneous CaO catalysts from eggshells prepared at different calcination temperatures
- Regeneration of spent mercury catalyst for the treatment of dye wastewater by the microwave and ultrasonic spray-assisted method
- Green synthesis of the innovative super paramagnetic nanoparticles from the leaves extract of Fraxinus chinensis Roxb and their application for the decolourisation of toxic dyes
- Biogenic ZnO nanoparticles: a study of blueshift of optical band gap and photocatalytic degradation of reactive yellow 186 dye under direct sunlight
- Leached compounds from the extracts of pomegranate peel, green coconut shell, and karuvelam wood for the removal of hexavalent chromium
- Enhancement of molecular weight reduction of natural rubber in triphasic CO2/toluene/H2O systems with hydrogen peroxide for preparation of biobased polyurethanes
- An efficient green synthesis of novel 1H-imidazo[1,2-a]imidazole-3-amine and imidazo[2,1-c][1,2,4]triazole-5-amine derivatives via Strecker reaction under controlled microwave heating
- Evaluation of three different green fabrication methods for the synthesis of crystalline ZnO nanoparticles using Pelargonium zonale leaf extract
- A highly efficient and multifunctional biomass supporting Ag, Ni, and Cu nanoparticles through wetness impregnation for environmental remediation
- Simple one-pot green method for large-scale production of mesalamine, an anti-inflammatory agent
- Relationships between step and cumulative PMI and E-factors: implications on estimating material efficiency with respect to charting synthesis optimization strategies
- A comparative sorption study of Cr3+ and Cr6+ using mango peels: kinetic, equilibrium and thermodynamic
- Effects of acid hydrolysis waste liquid recycle on preparation of microcrystalline cellulose
- Use of deep eutectic solvents as catalyst: A mini-review
- Microwave-assisted synthesis of pyrrolidinone derivatives using 1,1’-butylenebis(3-sulfo-3H-imidazol-1-ium) chloride in ethylene glycol
- Green and eco-friendly synthesis of Co3O4 and Ag-Co3O4: Characterization and photo-catalytic activity
- Adsorption optimized of the coal-based material and application for cyanide wastewater treatment
- Aloe vera leaf extract mediated green synthesis of selenium nanoparticles and assessment of their In vitro antimicrobial activity against spoilage fungi and pathogenic bacteria strains
- Waste phenolic resin derived activated carbon by microwave-assisted KOH activation and application to dye wastewater treatment
- Direct ethanol production from cellulose by consortium of Trichoderma reesei and Candida molischiana
- Agricultural waste biomass-assisted nanostructures: Synthesis and application
- Biodiesel production from rubber seed oil using calcium oxide derived from eggshell as catalyst – optimization and modeling studies
- Study of fabrication of fully aqueous solution processed SnS quantum dot-sensitized solar cell
- Assessment of aqueous extract of Gypsophila aretioides for inhibitory effects on calcium carbonate formation
- An environmentally friendly acylation reaction of 2-methylnaphthalene in solvent-free condition in a micro-channel reactor
- Aegle marmelos phytochemical stabilized synthesis and characterization of ZnO nanoparticles and their role against agriculture and food pathogen
- A reactive coupling process for co-production of solketal and biodiesel
- Optimization of the asymmetric synthesis of (S)-1-phenylethanol using Ispir bean as whole-cell biocatalyst
- Synthesis of pyrazolopyridine and pyrazoloquinoline derivatives by one-pot, three-component reactions of arylglyoxals, 3-methyl-1-aryl-1H-pyrazol-5-amines and cyclic 1,3-dicarbonyl compounds in the presence of tetrapropylammonium bromide
- Preconcentration of morphine in urine sample using a green and solvent-free microextraction method
- Extraction of glycyrrhizic acid by aqueous two-phase system formed by PEG and two environmentally friendly organic acid salts - sodium citrate and sodium tartrate
- Green synthesis of copper oxide nanoparticles using Juglans regia leaf extract and assessment of their physico-chemical and biological properties
- Deep eutectic solvents (DESs) as powerful and recyclable catalysts and solvents for the synthesis of 3,4-dihydropyrimidin-2(1H)-ones/thiones
- Biosynthesis, characterization and anti-microbial activity of silver nanoparticle based gel hand wash
- Efficient and selective microwave-assisted O-methylation of phenolic compounds using tetramethylammonium hydroxide (TMAH)
- Anticoagulant, thrombolytic and antibacterial activities of Euphorbia acruensis latex-mediated bioengineered silver nanoparticles
- Volcanic ash as reusable catalyst in the green synthesis of 3H-1,5-benzodiazepines
- Green synthesis, anionic polymerization of 1,4-bis(methacryloyl)piperazine using Algerian clay as catalyst
- Selenium supplementation during fermentation with sugar beet molasses and Saccharomyces cerevisiae to increase bioethanol production
- Biosynthetic potential assessment of four food pathogenic bacteria in hydrothermally silver nanoparticles fabrication
- Investigating the effectiveness of classical and eco-friendly approaches for synthesis of dialdehydes from organic dihalides
- Pyrolysis of palm oil using zeolite catalyst and characterization of the boil-oil
- Azadirachta indica leaves extract assisted green synthesis of Ag-TiO2 for degradation of Methylene blue and Rhodamine B dyes in aqueous medium
- Synthesis of vitamin E succinate catalyzed by nano-SiO2 immobilized DMAP derivative in mixed solvent system
- Extraction of phytosterols from melon (Cucumis melo) seeds by supercritical CO2 as a clean technology
- Production of uronic acids by hydrothermolysis of pectin as a model substance for plant biomass waste
- Biofabrication of highly pure copper oxide nanoparticles using wheat seed extract and their catalytic activity: A mechanistic approach
- Intelligent modeling and optimization of emulsion aggregation method for producing green printing ink
- Improved removal of methylene blue on modified hierarchical zeolite Y: Achieved by a “destructive-constructive” method
- Two different facile and efficient approaches for the synthesis of various N-arylacetamides via N-acetylation of arylamines and straightforward one-pot reductive acetylation of nitroarenes promoted by recyclable CuFe2O4 nanoparticles in water
- Optimization of acid catalyzed esterification and mixed metal oxide catalyzed transesterification for biodiesel production from Moringa oleifera oil
- Kinetics and the fluidity of the stearic acid esters with different carbon backbones
- Aiming for a standardized protocol for preparing a process green synthesis report and for ranking multiple synthesis plans to a common target product
- Microstructure and luminescence of VO2 (B) nanoparticle synthesis by hydrothermal method
- Optimization of uranium removal from uranium plant wastewater by response surface methodology (RSM)
- Microwave drying of nickel-containing residue: dielectric properties, kinetics, and energy aspects
- Simple and convenient two step synthesis of 5-bromo-2,3-dimethoxy-6-methyl-1,4-benzoquinone
- Biodiesel production from waste cooking oil
- The effect of activation temperature on structure and properties of blue coke-based activated carbon by CO2 activation
- Optimization of reaction parameters for the green synthesis of zero valent iron nanoparticles using pine tree needles
- Microwave-assisted protocol for squalene isolation and conversion from oil-deodoriser distillates
- Denitrification performance of rare earth tailings-based catalysts
- Facile synthesis of silver nanoparticles using Averrhoa bilimbi L and Plum extracts and investigation on the synergistic bioactivity using in vitro models
- Green production of AgNPs and their phytostimulatory impact
- Photocatalytic activity of Ag/Ni bi-metallic nanoparticles on textile dye removal
- Topical Issue: Green Process Engineering / Guest Editors: Martine Poux, Patrick Cognet
- Modelling and optimisation of oxidative desulphurisation of tyre-derived oil via central composite design approach
- CO2 sequestration by carbonation of olivine: a new process for optimal separation of the solids produced
- Organic carbonates synthesis improved by pervaporation for CO2 utilisation
- Production of starch nanoparticles through solvent-antisolvent precipitation in a spinning disc reactor
- A kinetic study of Zn halide/TBAB-catalysed fixation of CO2 with styrene oxide in propylene carbonate
- Topical on Green Process Engineering
Articles in the same Issue
- Regular Articles
- Studies on the preparation and properties of biodegradable polyester from soybean oil
- Flow-mode biodiesel production from palm oil using a pressurized microwave reactor
- Reduction of free fatty acids in waste oil for biodiesel production by glycerolysis: investigation and optimization of process parameters
- Saccharin: a cheap and mild acidic agent for the synthesis of azo dyes via telescoped dediazotization
- Optimization of lipase-catalyzed synthesis of polyethylene glycol stearate in a solvent-free system
- Green synthesis of iron oxide nanoparticles using Platanus orientalis leaf extract for antifungal activity
- Ultrasound assisted chemical activation of peanut husk for copper removal
- Room temperature silanization of Fe3O4 for the preparation of phenyl functionalized magnetic adsorbent for dispersive solid phase extraction for the extraction of phthalates in water
- Evaluation of the saponin green extraction from Ziziphus spina-christi leaves using hydrothermal, microwave and Bain-Marie water bath heating methods
- Oxidation of dibenzothiophene using the heterogeneous catalyst of tungsten-based carbon nanotubes
- Calcined sodium silicate as an efficient and benign heterogeneous catalyst for the transesterification of natural lecithin to L-α-glycerophosphocholine
- Synergistic effect between CO2 and H2O2 on ethylbenzene oxidation catalyzed by carbon supported heteropolyanion catalysts
- Hydrocyanation of 2-arylmethyleneindan-1,3-diones using potassium hexacyanoferrate(II) as a nontoxic cyanating agent
- Green synthesis of hydratropic aldehyde from α-methylstyrene catalyzed by Al2O3-supported metal phthalocyanines
- Environmentally benign chemical recycling of polycarbonate wastes: comparison of micro- and nano-TiO2 solid support efficiencies
- Medicago polymorpha-mediated antibacterial silver nanoparticles in the reduction of methyl orange
- Production of value-added chemicals from esterification of waste glycerol over MCM-41 supported catalysts
- Green synthesis of zerovalent copper nanoparticles for efficient reduction of toxic azo dyes congo red and methyl orange
- Optimization of the biological synthesis of silver nanoparticles using Penicillium oxalicum GRS-1 and their antimicrobial effects against common food-borne pathogens
- Optimization of submerged fermentation conditions to overproduce bioethanol using two industrial and traditional Saccharomyces cerevisiae strains
- Extraction of In3+ and Fe3+ from sulfate solutions by using a 3D-printed “Y”-shaped microreactor
- Foliar-mediated Ag:ZnO nanophotocatalysts: green synthesis, characterization, pollutants degradation, and in vitro biocidal activity
- Green cyclic acetals production by glycerol etherification reaction with benzaldehyde using cationic acidic resin
- Biosynthesis, characterization and antimicrobial activities assessment of fabricated selenium nanoparticles using Pelargonium zonale leaf extract
- Synthesis of high surface area magnesia by using walnut shell as a template
- Controllable biosynthesis of silver nanoparticles using actinobacterial strains
- Green vegetation: a promising source of color dyes
- Mechano-chemical synthesis of ammonia and acetic acid from inorganic materials in water
- Green synthesis and structural characterization of novel N1-substituted 3,4-dihydropyrimidin-2(1H)-ones
- Biodiesel production from cotton oil using heterogeneous CaO catalysts from eggshells prepared at different calcination temperatures
- Regeneration of spent mercury catalyst for the treatment of dye wastewater by the microwave and ultrasonic spray-assisted method
- Green synthesis of the innovative super paramagnetic nanoparticles from the leaves extract of Fraxinus chinensis Roxb and their application for the decolourisation of toxic dyes
- Biogenic ZnO nanoparticles: a study of blueshift of optical band gap and photocatalytic degradation of reactive yellow 186 dye under direct sunlight
- Leached compounds from the extracts of pomegranate peel, green coconut shell, and karuvelam wood for the removal of hexavalent chromium
- Enhancement of molecular weight reduction of natural rubber in triphasic CO2/toluene/H2O systems with hydrogen peroxide for preparation of biobased polyurethanes
- An efficient green synthesis of novel 1H-imidazo[1,2-a]imidazole-3-amine and imidazo[2,1-c][1,2,4]triazole-5-amine derivatives via Strecker reaction under controlled microwave heating
- Evaluation of three different green fabrication methods for the synthesis of crystalline ZnO nanoparticles using Pelargonium zonale leaf extract
- A highly efficient and multifunctional biomass supporting Ag, Ni, and Cu nanoparticles through wetness impregnation for environmental remediation
- Simple one-pot green method for large-scale production of mesalamine, an anti-inflammatory agent
- Relationships between step and cumulative PMI and E-factors: implications on estimating material efficiency with respect to charting synthesis optimization strategies
- A comparative sorption study of Cr3+ and Cr6+ using mango peels: kinetic, equilibrium and thermodynamic
- Effects of acid hydrolysis waste liquid recycle on preparation of microcrystalline cellulose
- Use of deep eutectic solvents as catalyst: A mini-review
- Microwave-assisted synthesis of pyrrolidinone derivatives using 1,1’-butylenebis(3-sulfo-3H-imidazol-1-ium) chloride in ethylene glycol
- Green and eco-friendly synthesis of Co3O4 and Ag-Co3O4: Characterization and photo-catalytic activity
- Adsorption optimized of the coal-based material and application for cyanide wastewater treatment
- Aloe vera leaf extract mediated green synthesis of selenium nanoparticles and assessment of their In vitro antimicrobial activity against spoilage fungi and pathogenic bacteria strains
- Waste phenolic resin derived activated carbon by microwave-assisted KOH activation and application to dye wastewater treatment
- Direct ethanol production from cellulose by consortium of Trichoderma reesei and Candida molischiana
- Agricultural waste biomass-assisted nanostructures: Synthesis and application
- Biodiesel production from rubber seed oil using calcium oxide derived from eggshell as catalyst – optimization and modeling studies
- Study of fabrication of fully aqueous solution processed SnS quantum dot-sensitized solar cell
- Assessment of aqueous extract of Gypsophila aretioides for inhibitory effects on calcium carbonate formation
- An environmentally friendly acylation reaction of 2-methylnaphthalene in solvent-free condition in a micro-channel reactor
- Aegle marmelos phytochemical stabilized synthesis and characterization of ZnO nanoparticles and their role against agriculture and food pathogen
- A reactive coupling process for co-production of solketal and biodiesel
- Optimization of the asymmetric synthesis of (S)-1-phenylethanol using Ispir bean as whole-cell biocatalyst
- Synthesis of pyrazolopyridine and pyrazoloquinoline derivatives by one-pot, three-component reactions of arylglyoxals, 3-methyl-1-aryl-1H-pyrazol-5-amines and cyclic 1,3-dicarbonyl compounds in the presence of tetrapropylammonium bromide
- Preconcentration of morphine in urine sample using a green and solvent-free microextraction method
- Extraction of glycyrrhizic acid by aqueous two-phase system formed by PEG and two environmentally friendly organic acid salts - sodium citrate and sodium tartrate
- Green synthesis of copper oxide nanoparticles using Juglans regia leaf extract and assessment of their physico-chemical and biological properties
- Deep eutectic solvents (DESs) as powerful and recyclable catalysts and solvents for the synthesis of 3,4-dihydropyrimidin-2(1H)-ones/thiones
- Biosynthesis, characterization and anti-microbial activity of silver nanoparticle based gel hand wash
- Efficient and selective microwave-assisted O-methylation of phenolic compounds using tetramethylammonium hydroxide (TMAH)
- Anticoagulant, thrombolytic and antibacterial activities of Euphorbia acruensis latex-mediated bioengineered silver nanoparticles
- Volcanic ash as reusable catalyst in the green synthesis of 3H-1,5-benzodiazepines
- Green synthesis, anionic polymerization of 1,4-bis(methacryloyl)piperazine using Algerian clay as catalyst
- Selenium supplementation during fermentation with sugar beet molasses and Saccharomyces cerevisiae to increase bioethanol production
- Biosynthetic potential assessment of four food pathogenic bacteria in hydrothermally silver nanoparticles fabrication
- Investigating the effectiveness of classical and eco-friendly approaches for synthesis of dialdehydes from organic dihalides
- Pyrolysis of palm oil using zeolite catalyst and characterization of the boil-oil
- Azadirachta indica leaves extract assisted green synthesis of Ag-TiO2 for degradation of Methylene blue and Rhodamine B dyes in aqueous medium
- Synthesis of vitamin E succinate catalyzed by nano-SiO2 immobilized DMAP derivative in mixed solvent system
- Extraction of phytosterols from melon (Cucumis melo) seeds by supercritical CO2 as a clean technology
- Production of uronic acids by hydrothermolysis of pectin as a model substance for plant biomass waste
- Biofabrication of highly pure copper oxide nanoparticles using wheat seed extract and their catalytic activity: A mechanistic approach
- Intelligent modeling and optimization of emulsion aggregation method for producing green printing ink
- Improved removal of methylene blue on modified hierarchical zeolite Y: Achieved by a “destructive-constructive” method
- Two different facile and efficient approaches for the synthesis of various N-arylacetamides via N-acetylation of arylamines and straightforward one-pot reductive acetylation of nitroarenes promoted by recyclable CuFe2O4 nanoparticles in water
- Optimization of acid catalyzed esterification and mixed metal oxide catalyzed transesterification for biodiesel production from Moringa oleifera oil
- Kinetics and the fluidity of the stearic acid esters with different carbon backbones
- Aiming for a standardized protocol for preparing a process green synthesis report and for ranking multiple synthesis plans to a common target product
- Microstructure and luminescence of VO2 (B) nanoparticle synthesis by hydrothermal method
- Optimization of uranium removal from uranium plant wastewater by response surface methodology (RSM)
- Microwave drying of nickel-containing residue: dielectric properties, kinetics, and energy aspects
- Simple and convenient two step synthesis of 5-bromo-2,3-dimethoxy-6-methyl-1,4-benzoquinone
- Biodiesel production from waste cooking oil
- The effect of activation temperature on structure and properties of blue coke-based activated carbon by CO2 activation
- Optimization of reaction parameters for the green synthesis of zero valent iron nanoparticles using pine tree needles
- Microwave-assisted protocol for squalene isolation and conversion from oil-deodoriser distillates
- Denitrification performance of rare earth tailings-based catalysts
- Facile synthesis of silver nanoparticles using Averrhoa bilimbi L and Plum extracts and investigation on the synergistic bioactivity using in vitro models
- Green production of AgNPs and their phytostimulatory impact
- Photocatalytic activity of Ag/Ni bi-metallic nanoparticles on textile dye removal
- Topical Issue: Green Process Engineering / Guest Editors: Martine Poux, Patrick Cognet
- Modelling and optimisation of oxidative desulphurisation of tyre-derived oil via central composite design approach
- CO2 sequestration by carbonation of olivine: a new process for optimal separation of the solids produced
- Organic carbonates synthesis improved by pervaporation for CO2 utilisation
- Production of starch nanoparticles through solvent-antisolvent precipitation in a spinning disc reactor
- A kinetic study of Zn halide/TBAB-catalysed fixation of CO2 with styrene oxide in propylene carbonate
- Topical on Green Process Engineering